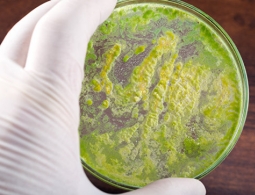
Медики предупредили об угрозе супербактерии, вызывающей бесплодие

Между двумя японскими вулканами нашли подземную связь
Впервые в истории ученые нашли подтверждение тому, что радикальные изменения одного вулкана на юге Японии стали прямым следствием извержения другого вулкана в 22 километрах от него. Наблюдения двух этих вулканов – Айра и Кирисима – показали, что они были связаны одним источником подповер...
Медики предупредили об угрозе супербактерии, вызывающей бесплодие
Исследователи из Британской ассоциации сексуального здоровья и ВИЧ (BASHH) обнаружили новую потенциальную супербактерию Mycoplasma genitalium (M. genitalium), которая в течение 10 лет может стать устойчивой к любым видам антибиотиков. Соответствующее исследование опубликовано на&...
Ученые выяснили, что ел человек пять тысяч лет назад
Группа ученых под руководством итальянского исследовательского центра Eurac Research провела анализ содержимого желудка 5300-летней мумии человека Эци, в ходе которого установила, что стало его последней пищей, говорится в опубликованном в журнале Current Biologyисследовании...
Ученые рассказали о падении солнечной активности
Солнечная активность летом 2018 года упала до нуля, и даже большие группы пятен, появляющиеся на солнечном диске, уже не способны на производство вспышек, констатируют российские ученые.Такие выводы подтверждают текущие наблюдения одной из наиболее крупных активных...
Физики раскрыли загадку знаменитого Базельского папируса
Физики выяснили, что загадочный Базельский папирус, о происхождении которого историки спорят уже четыре века, представляет собой медицинский трактат знаменитого римского врача Клавдия Галена, сообщает пресс-служба Университета Базеля."Это сенсационное открытие. Теперь мы точн...
Интервью с главой первого космического государства Асгардия: о надеждах и планах на будущее
Асгардия – мечта фантастов, становящаяся реальностью. Первое космическое общество, независимое от политики и управления земными законами. С момента основания Асгардии в 2016 году ее лидером де-факто являлся российский предприниматель, ученый и доктор технических наук Игорь Ашурбейли. Однако 25...
Ученые сообщили о затмении Солнца суперлуной в пятницу 13-го
Частное затмение Солнца, которое можно будет наблюдать в Австралии и Антарктиде, произойдет в пятницу, 13 июля, сообщила пресс-служба Московского планетария.Уточняется, что на территории России, а также во всем Северном полушарии планеты феномен разглядеть будет нев...
Ученые выяснили, почему лошади фыркают
Фыркание лошадей оказалось знаком позитивных эмоций и символом одобрения действий хозяина, заявляют зоологи, опубликовавшие статью в журнале PLoS One."Наши наблюдения показали, что лошади чаще фыркают во время приятных событий в их жизни — к примеру,...
"Очеловечивание человека": почему собаки так хорошо понимают людей
Собаки распознают интонации и смысл слов, чувствуют эмоции человека по выражению его лица и сами общаются с помощью мимики. За что четвероногие питомцы любят хозяев и почему их предки одомашнились — в материале РИА Новости.В феврале 2015 года ученые,...
Ученые выяснили, как появляется болезнь Альцгеймера
Ученые из Юго-Западного Медицинского центра Техасского Университета в США совершили прорыв в изучении болезни Альцгеймера — им удалось выяснить, где и как зарождается заболевание. Результаты исследования опубликованы в научном журнале eLife.При болезни Ал...
Соседняя "кузина" Земли должна быть обитаемой, заявляют астрономы
Ближайшая к нам землеподобная планета Ross 128b, удаленная от Земли всего на 11 световых лет, должна иметь "земной" состав недр и мягкий климат. Это повышает шансы на существование жизни на ее поверхности, заявляют астрономы в статье, опубликованной в&nbs...
Спектральный анализ ближайшей экзопланеты повысил потенциал ее обитаемости
В прошлом году астрономы объявили об открытии экзопланеты всего в 11 световых годах от Земли. И не просто очередной экзопланеты, а скалистой экзопланеты, предположительно обладающей большим потенциалом для обитаемости. Новая группа исследователей провела более глубокий анализ открытого мир...